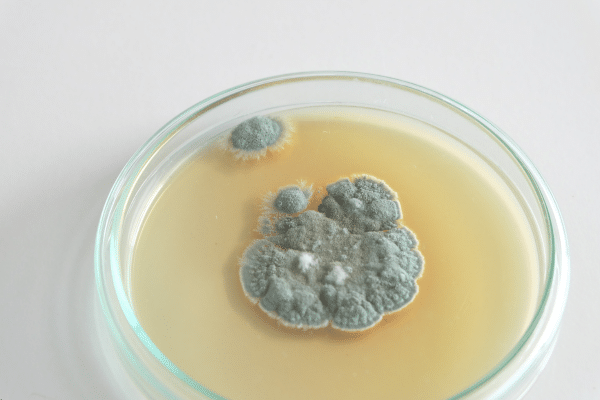
Fungal Infection

A deadly fungal infection is rapidly spreading through hospitals across the United States, raising alarms among health officials. Candida auris, a fungus first identified in 2009, is making a dramatic comeback with a staggering spike in cases in recent years. Once a rare occurrence, C. auris infections are now emerging at an unprecedented rate and in more varied forms than ever before.
Candida auris Declared a Top Threat in US Hospitals
According to the Centers for Disease Control and Prevention (CDC), Candida auris is now officially classified as an “urgent antimicrobial resistance threat.” First reported in the US in 2016, the fungus is known for its ability to resist traditional antifungal treatments and withstand common disinfectants used in hospitals.
Health systems are under mounting pressure to adapt quickly. A recent focus on one major hospital network in Miami, Florida, revealed an alarming trend. Infections in that system surged from only five reported cases in 2019 to 115 in 2023. That 2,200 percent increase has raised urgent questions about the fungus’s rapid spread and its evolving ability to survive typical containment methods.
Hospitals Struggle to Contain a Stealthy Invader
The Miami-based study observed a sharp increase in clinical cultures testing positive for C. auris in 2020 and 2021, followed by a continued but slower rise in 2022 and 2023. Hospital-acquired infections appear to be the primary source of transmission, with the fungus often spreading through catheters, feeding tubes, and breathing equipment. These environments make it easier for C. auris to jump from patient to patient.
Compounding the concern, many strains of C. auris are resistant to standard antifungal medications and fail to respond to conventional hospital-grade disinfectants. That makes containment especially difficult in intensive care units and other vulnerable hospital wards.
The Hidden Danger: Who is Most at Risk?
Despite the alarming numbers, Candida auris does not currently pose a major risk to the general population. Most healthy individuals are unlikely to encounter or be affected by the fungus. However, patients already hospitalized or those with compromised immune systems face far greater risk.
In these high-risk groups, C. auris can cause life-threatening infections. Bloodstream infections remain the most commonly reported, but infections in soft tissue, bones, and even cerebrospinal fluid are becoming more frequent. This expanding range of infection sites makes detection and treatment far more complicated for healthcare providers.
A Growing Global Health Crisis
While the spotlight is currently on the US, C. auris is far from a local issue. Countries across the globe have been grappling with outbreaks for over a decade. Health systems worldwide are now facing similar challenges, including drug resistance and difficulty in preventing the spread within medical facilities.


